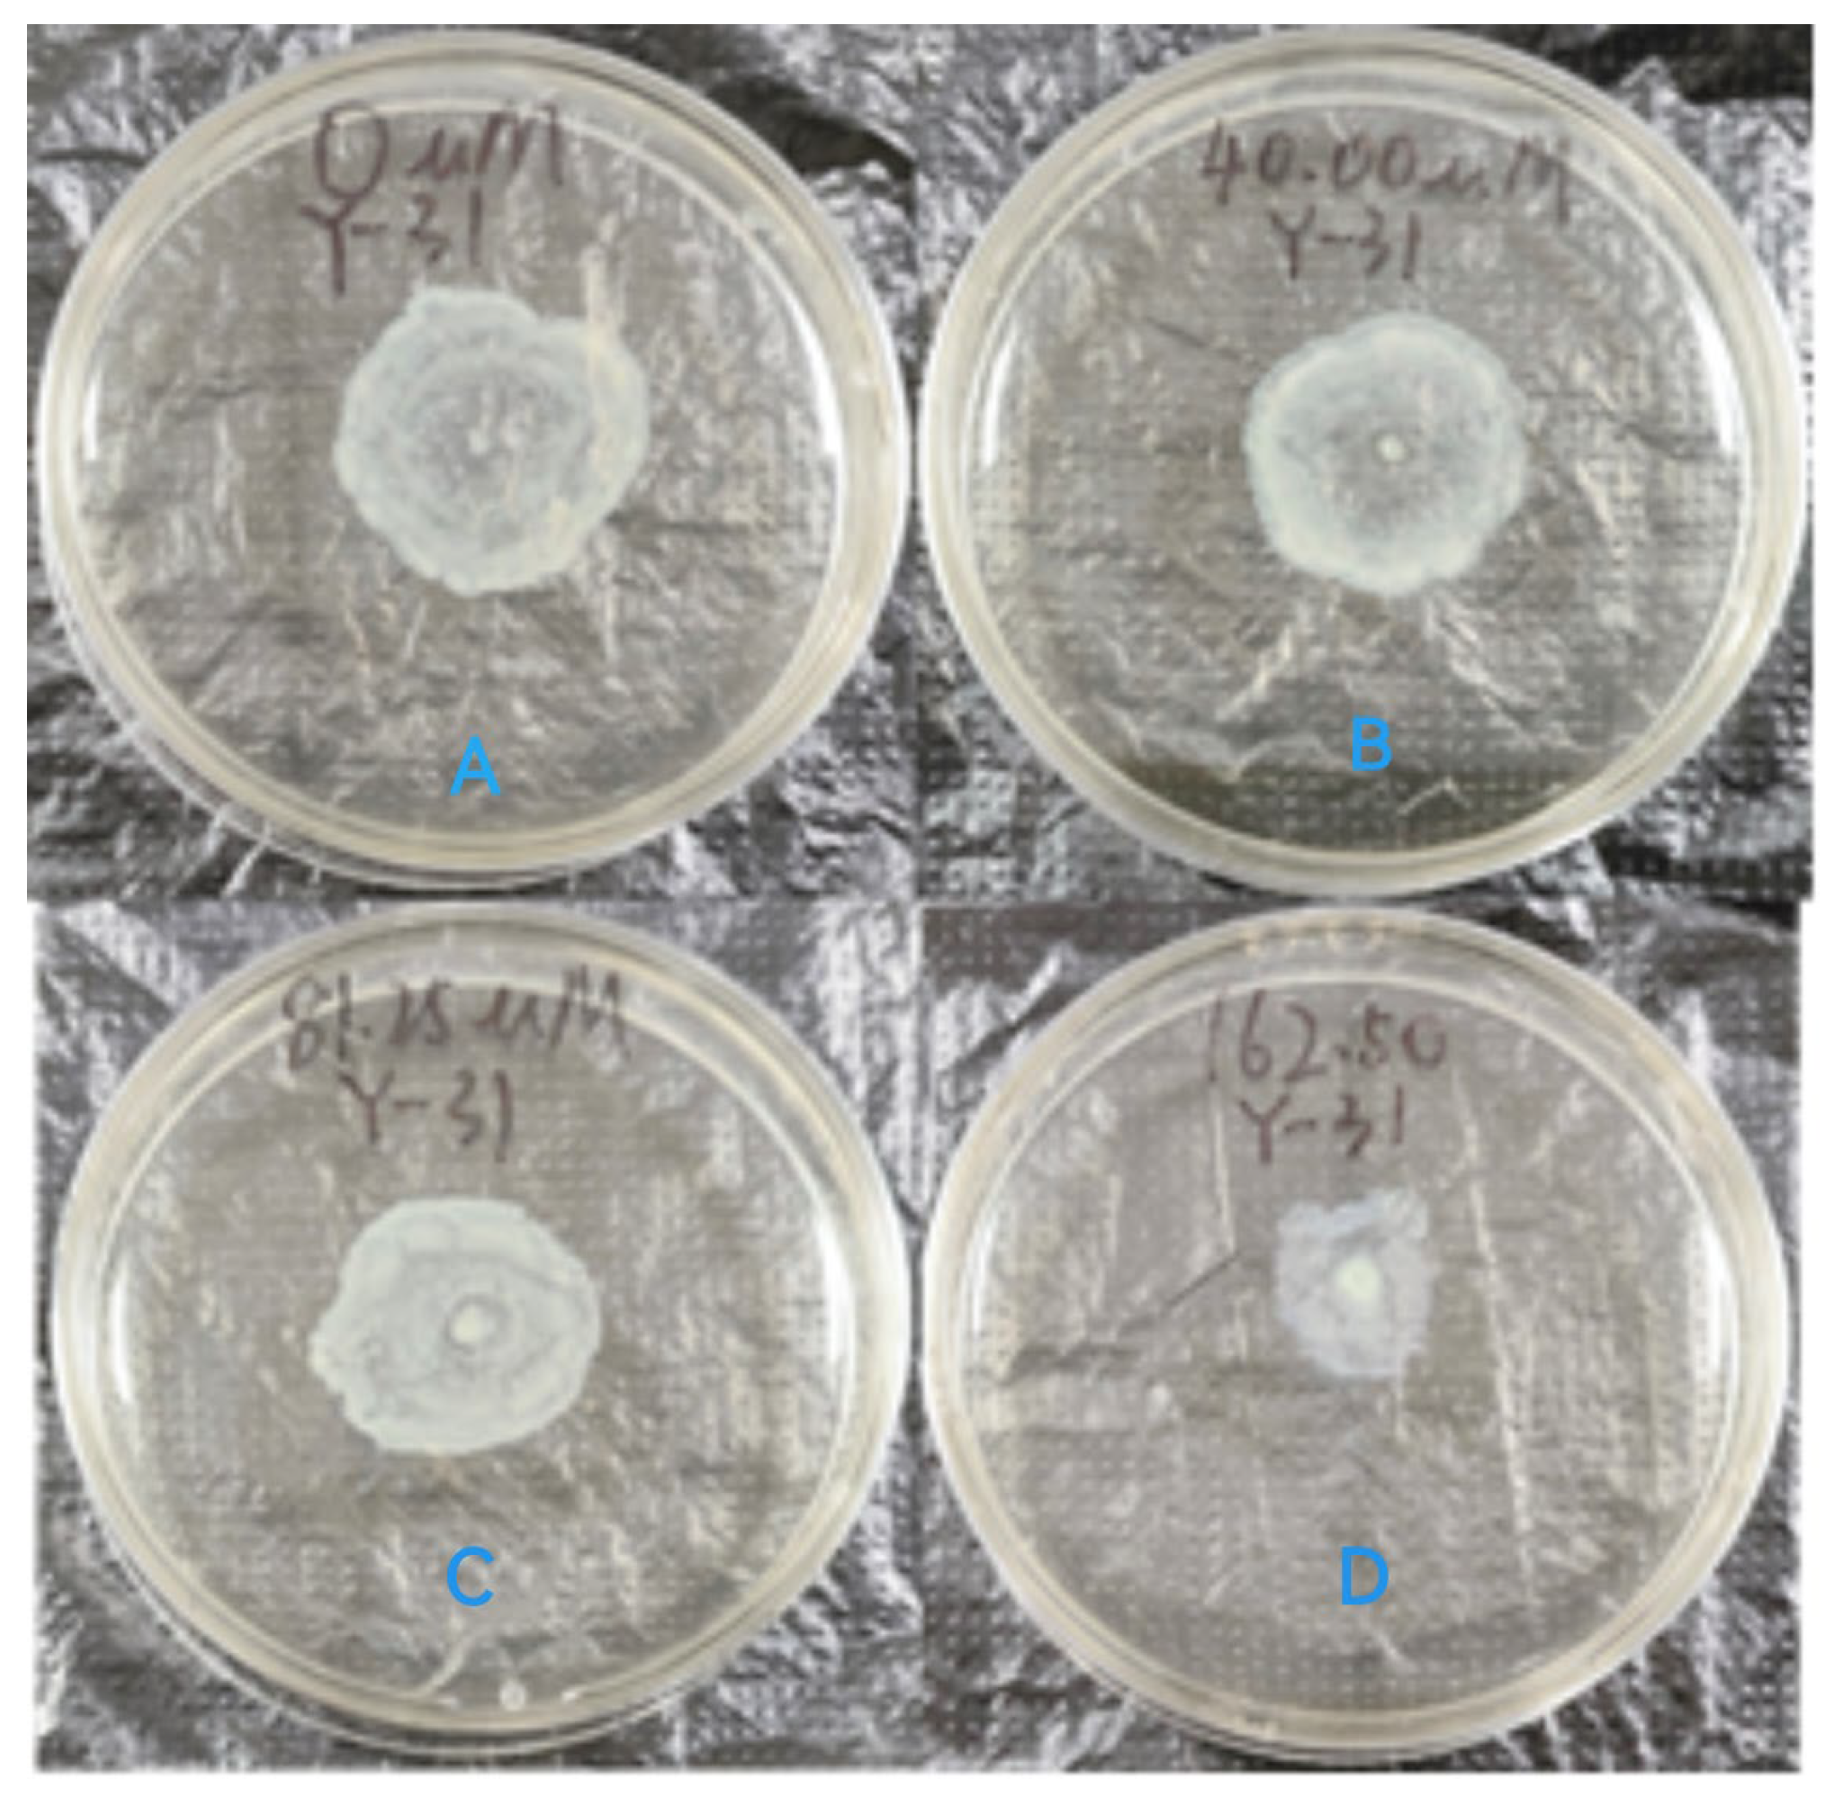
Molecules 29 02211 g009

Design, Synthesis, and Biological Evaluation of the Quorum-Sensing Inhibitors of Pseudomonas aeruginosa PAO1
Abstract
1. Introduction
2. Results and Discussion
2.1. Chemistry
2.1.1. Analysis of the Interaction between AOZ-1 and CviR Protein and the Design of Its Derivatives and Synthesis
2.1.2. Analysis of Inhibition of C. violaceum QS Activity, Screening, and SAR Analysis of AOZ-1 Derivatives
2.1.3. Design and Activity Screening of the New Parent Nucleus
2.2. The Effect of the Compounds on P. aeruginosa Biofilm Formation
2.3. The Analysis of Growth Activity of Y-31 against PAO1
2.4. The Effect of Y-31 on P. aeruginosa Virulence Factors
2.5. The Effect of Y-31 on the Survival of Infected C. elegans
2.6. The Cytotoxicity Test
2.7. ADMET
3. Materials and Methods
3.1. General Chemistry
3.2. Biological Assays
3.2.1. Medium, Bacterial Strains, and Experimental Drugs
3.2.2. The Half-Maximal Inhibitory Concentration (IC50) of Compounds against C. violaceum CV026 QS [36]
3.2.3. Biofilm Quantification Assays
3.2.4. The Growth of the Compound of PAO1 QS Activity Analysis
3.2.5. Virulence Factor Quantification Analysis
3.2.6. Swarming Motility Analysis
3.2.7. C. elegans Survival Assay
3.2.8. Cytotoxicity Test
- Cell Culture
- 2.
- CCK8 Detection of Cell Proliferation
3.2.9. Pharmacokinetics
4. Conclusions
Supplementary Materials
Author Contributions
Funding
Institutional Review Board Statement
Informed Consent Statement
Data Availability Statement
Conflicts of Interest
References
- Defoirdt, T. Antivirulence therapy for animal production: Filling an arsenal with novel weapons for sustainable disease control. PLoS Pathog. 2013, 9, e1003603. [Google Scholar] [CrossRef] [PubMed]
- Kalia, V.C. Quorum sensing inhibitors: An overview. Biotechnol. Adv. 2013, 31, 224–245. [Google Scholar] [CrossRef] [PubMed]
- Waters, C.M.; Bassler, B.L. Quorum sensing: Cell-to-cell communication in bacteria. Annu. Rev. Cell Dev. Biol. 2005, 21, 319–346. [Google Scholar] [CrossRef] [PubMed]
- Choudhary, S.; Schmidt-Dannert, C. Applications of quorum sensing in biotechnology. Appl. Microbiol. Biotechnol. 2010, 86, 1267–1279. [Google Scholar] [CrossRef] [PubMed]
- Van Delden, C.; Iglewski, B.H. Cell-to-Cell Signaling and Pseudomonas aeruginosa Infections. Emerg. Infect. Dis. 1998, 4, 551–560. [Google Scholar] [CrossRef] [PubMed]
- Oliver, A.; Mulet, X.; Lopez-Causape, C.; Juan, C. The increasing threat of Pseudomonas aeruginosa high-risk clones. Drug Resist. Updat. 2015, 21–22, 41–59. [Google Scholar] [CrossRef]
- Vandeputte, O.M.; Kiendrebeogo, M.; Rajaonson, S.; Diallo, B.; Mol, A.; El Jaziri, M.; Baucher, M. Identification of catechin as one of the flavonoids from Combretum albiflorum bark extract that reduces the production of quorum-sensing-controlled virulence factors in Pseudomonas aeruginosa PAO1. Appl. Environ. Microbiol. 2010, 76, 243–253. [Google Scholar] [CrossRef] [PubMed]
- Chourasiya, S.S.; Kathuria, D.; Singh, S.; Sonawane, V.C.; Chakraborti, A.K.; Bharatam, P.V. Design, synthesis and biological evaluation of novel unsymmetrical azines as quorum sensing inhibitors. RSC Adv. 2015, 5, 80027–80038. [Google Scholar] [CrossRef]
- Duerkop, B.A.; Varga, J.; Chandler, J.R.; Peterson, S.B.; Herman, J.P.; Churchill, M.E.; Parsek, M.R.; Nierman, W.C.; Greenberg, E.P. Quorum-sensing control of antibiotic synthesis in Burkholderia thailandensis. J. Bacteriol. 2009, 191, 3909–3918. [Google Scholar] [CrossRef] [PubMed]
- Duerkop, B.A.; Ulrich, R.L.; Greenberg, E.P. Octanoyl-homoserine lactone is the cognate signal for Burkholderia mallei BmaR1-BmaI1 quorum sensing. J. Bacteriol. 2007, 189, 5034–5040. [Google Scholar] [CrossRef]
- Duerkop, B.A.; Herman, J.P.; Ulrich, R.L.; Churchill, M.E.; Greenberg, E.P. The Burkholderia mallei BmaR3-BmaI3 quorum-sensing system produces and responds to N-3-hydroxy-octanoyl homoserine lactone. J. Bacteriol. 2008, 190, 5137–5141. [Google Scholar] [CrossRef] [PubMed]
- Gambello, M.J.; Kaye, S.; Iglewski, B.H. LasR of Pseudomonas aeruginosa is a transcriptional activator of the alkaline protease gene (apr) and an enhancer of exotoxin A expression. Infect. Immun. 1993, 61, 1180–1184. [Google Scholar] [CrossRef] [PubMed]
- Brint, J.M.; Ohman, D.E. Synthesis of multiple exoproducts in Pseudomonas aeruginosa is under the control of RhlR-RhlI, another set of regulators in strain PAO1 with homology to the autoinducer-responsive LuxR-LuxI family. J. Bacteriol. 1995, 177, 7155–7163. [Google Scholar] [CrossRef]
- Winson, M.K.; Camara, M.; Latifi, A.; Foglino, M.; Chhabra, S.R.; Daykin, M.; Bally, M.; Chapon, V.; Salmond, G.P.; Bycroft, B.W. Multiple N-acyl-L-homoserine lactone signal molecules regulate production of virulence determinants and secondary metabolites in Pseudomonas aeruginosa. Proc. Natl. Acad. Sci. USA 1995, 92, 9427–9431. [Google Scholar] [CrossRef] [PubMed]
- Diggle, S.P.; Winzer, K.; Chhabra, S.R.; Worrall, K.E.; Camara, M.; Williams, P. The Pseudomonas aeruginosa quinolone signal molecule overcomes the cell density-dependency of the quorum sensing hierarchy, regulates rhl-dependent genes at the onset of stationary phase and can be produced in the absence of LasR. Mol. Microbiol. 2003, 50, 29–43. [Google Scholar] [CrossRef] [PubMed]
- McGrath, S.; Wade, D.S.; Pesci, E.C. Dueling quorum sensing systems in Pseudomonas aeruginosa control the production of the Pseudomonas quinolone signal (PQS). FEMS Microbiol. Lett. 2004, 230, 27–34. [Google Scholar] [CrossRef]
- Lee, J.; Zhang, L. The hierarchy quorum sensing network in Pseudomonas aeruginosa. Protein Cell 2015, 6, 26–41. [Google Scholar] [CrossRef]
- Sabbah, M.; Fontaine, F.; Grand, L.; Boukraa, M.; Efrit, M.L.; Doutheau, A.; Soulere, L.; Queneau, Y. Synthesis and biological evaluation of new N-acyl-homoserine-lactone analogues, based on triazole and tetrazole scaffolds, acting as LuxR-dependent quorum sensing modulators. Bioorganic Med. Chem. 2012, 20, 4727–4736. [Google Scholar] [CrossRef] [PubMed]
- Li, Q.; Mao, S.; Wang, H.; Ye, X. The Molecular Architecture of Pseudomonas aeruginosa Quorum-Sensing Inhibitors. Mar. Drugs 2022, 20, 488. [Google Scholar] [CrossRef]
- Eberhard, A.; Widrig, C.A.; McBath, P.; Schineller, J.B. Analogs of the autoinducer of bioluminescence in Vibrio fischeri. Arch. Microbiol. 1986, 146, 35–40. [Google Scholar] [CrossRef]
- Kalaiarasan, E.; Thirumalaswamy, K.; Harish, B.N.; Gnanasambandam, V.; Sali, V.K.; John, J. Inhibition of quorum sensing-controlled biofilm formation in Pseudomonas aeruginosa by quorum-sensing inhibitors. Microb. Pathog. 2017, 111, 99–107. [Google Scholar] [CrossRef] [PubMed]
- Luo, C.; Li, P.; Liu, H.; Feng, P.; Li, J.; Zhao, L.; Wu, C.L. Synthesis of novel chalcone-based L-homoserine lactones and theirquorum sensing inhibitory activity evaluation. Russ. J. Bioorganic Chem. 2020, 46, 139–148. [Google Scholar]
- Moore, J.D.; Gerdt, J.P.; Eibergen, N.R.; Blackwell, H.E. Active efflux influences the potency of quorum sensing inhibitors in Pseudomonas aeruginosa. Chembiochem 2014, 15, 435–442. [Google Scholar] [CrossRef] [PubMed]
- Mingming, Z. Design, Sythsis and Evaluation of Bacterial Quorum Sensing Inhibitors. Ph.D. Thesis, Shengyang Pharmaceutical University, Shengyang, China, 2013. [Google Scholar]
- Chen, G.; Swem, L.R.; Swem, D.L.; Stauff, D.L.; O’Loughlin, C.T.; Jeffrey, P.D.; Bassler, B.L.; Hughson, F.M. A strategy for antagonizing quorum sensing. Mol. Cell 2011, 42, 199–209. [Google Scholar] [CrossRef] [PubMed]
- Jiang, K.; Yan, X.; Yu, J.; Xiao, Z.; Wu, H.; Zhao, M.; Yue, Y.; Zhou, X.; Xiao, J.; Lin, F. Design, synthesis, and biological evaluation of 3-amino-2-oxazolidinone derivatives as potent quorum-sensing inhibitors of Pseudomonas aeruginosa PAO1. Eur. J. Med. Chem. 2020, 194, 112252. [Google Scholar] [CrossRef] [PubMed]
- McClean, K.H.; Winson, M.K.; Fish, L.; Taylor, A.; Chhabra, S.R.; Camara, M.; Daykin, M.; Lamb, J.H.; Swift, S.; Bycroft, B.W.; et al. Quorum sensing and Chromobacterium violaceum: Exploitation of violacein production and inhibition for the detection of N-acylhomoserine lactones. Microbiology 1997, 143, 3703–3711. [Google Scholar] [CrossRef]
- Allen, R.C.; Popat, R.; Diggle, S.P.; Brown, S.P. Targeting virulence: Can we make evolution-proof drugs? Nat. Rev. Microbiol. 2014, 12, 300–308. [Google Scholar] [CrossRef]
- Dietrich, L.E.; Price-Whelan, A.; Petersen, A.; Whiteley, M.; Newman, D.K. The phenazine pyocyanin is a terminal signalling factor in the quorum sensing network of Pseudomonas aeruginosa. Mol. Microbiol. 2006, 61, 1308–1321. [Google Scholar] [CrossRef]
- Wilson, R.; Sykes, D.A.; Watson, D.; Rutman, A.; Taylor, G.W.; Cole, P. Measurement of Pseudomonas aeruginosa phenazine pigments in sputum and assessment of their contribution to sputum sol toxicity for respiratory epithelium. Infect. Immun. 1988, 56, 2515–2517. [Google Scholar] [CrossRef]
- Jensen, P.O.; Bjarnsholt, T.; Phipps, R.; Rasmussen, T.B.; Calum, H.; Christoffersen, L.; Moser, C.; Williams, P.; Pressler, T.; Givskov, M.; et al. Rapid necrotic killing of polymorphonuclear leukocytes is caused by quorum-sensing-controlled production of rhamnolipid by Pseudomonas aeruginosa. Microbiology 2007, 153, 1329–1338. [Google Scholar] [CrossRef]
- Welsh, M.A.; Eibergen, N.R.; Moore, J.D.; Blackwell, H.E. Small molecule disruption of quorum sensing cross-regulation in Pseudomonas aeruginosa causes major and unexpected alterations to virulence phenotypes. J. Am. Chem. Soc. 2015, 137, 1510–1519. [Google Scholar] [CrossRef]
- Amrit, F.R.; Ratnappan, R.; Keith, S.A.; Ghazi, A. The C. elegans lifespan assay toolkit. Methods 2014, 68, 465–475. [Google Scholar] [CrossRef]
- Adonizio, A.; Leal, S.M.; Ausubel, F.M.; Mathee, K. Attenuation of Pseudomonas aeruginosa virulence by medicinal plants in a Caenorhabditis elegans model system. J. Med. Microbiol. 2008, 57, 809–813. [Google Scholar] [CrossRef] [PubMed]
- Mahajan-Miklos, S.; Tan, M.W.; Rahme, L.G.; Ausubel, F.M. Molecular Mechanisms of Bacterial Virulence Elucidated Using a Pseudomonas aeruginosa—Caenorhabditis elegans Pathogenesis Model. Cell 1999, 96, 47–56. [Google Scholar] [CrossRef]
- Poli, J.P.; Guinoiseau, E.; de Rocca Serra, D.; Sutour, S.; Paoli, M.; Tomi, F.; Quilichini, Y.; Berti, L.; Lorenzi, V. Anti-Quorum Sensing Activity of 12 Essential Oils on chromobacterium violaceum and Specific Action of cis-cis-p-Menthenolide from Corsican Mentha suaveolens ssp. Insularis. Molecules 2018, 23, 2125. [Google Scholar] [CrossRef] [PubMed]
- Brackman, G.; Risseeuw, M.; Celen, S.; Cos, P.; Maes, L.; Nelis, H.J.; Van Calenbergh, S.; Coenye, T. Synthesis and evaluation of the quorum sensing inhibitory effect of substituted triazolyldihydrofuranones. Bioorganic Med. Chem. 2012, 20, 4737–4743. [Google Scholar] [CrossRef]
- Essar, D.W.; Eberly LE, E.; Hadero, A.; Crawford, I.P. Identification and characterization of genes for a second anthranilate synthase in Pseudomonas aeruginosa: Interchangeability of the two anthranilate synthases and evolutionary implications. J. Bacteriol. 1990, 172, 884–900. [Google Scholar] [CrossRef]
- Liu, J.; Meng, Y.; Yang, M.H.; Zhang, X.Y.; Zhao, J.F.; Sun, P.H.; Chen, W.M. Design, synthesis and biological evaluation of novel 3-hydroxypyridin-4(1H)-ones based hybrids as Pseudomonas aeruginosa biofilm inhibitors. Eur. J. Med. Chem. 2023, 259, 115665. [Google Scholar] [CrossRef] [PubMed]
- Tremblay, J.; Deziel, E. Improving the reproducibility of Pseudomonas aeruginosa swarming motility assays. J. Basic. Microbiol. 2008, 48, 509–515. [Google Scholar] [CrossRef]
- Rajkumari, J.; Borkotoky, S.; Murali, A.; Suchiang, K.; Mohanty, S.K.; Busi, S. Attenuation of quorum sensing controlled virulence factors and biofilm formation in Pseudomonas aeruginosa by pentacyclic triterpenes, betulin and betulinic acid. Microb. Pathog. 2018, 118, 48–60. [Google Scholar] [CrossRef]

| Number | Structure | IC50 (µM) |
|---|---|---|
| Y-1 | ![]() | 198.93 ± 13.88 |
| Y-2 | ![]() | NA |
| Y-3 | ![]() | 208.33 ± 7.26 |
| Y-5 | ![]() | 125.17 ± 16.05 |
| Y-8 | ![]() | NA |
| Y-9 | ![]() | 167.77 ± 7.28 |
| Y-11 | ![]() | NA |
| Y-15 | ![]() | 91.33 ± 3.02 |
| Y-16 | ![]() | NA |
| Y-17 | ![]() | >260 |
| Y-18 | ![]() | >260 |
| Y-19 | ![]() | 152.6 ± 8.78 |
| Y-24 | ![]() | NA |
| Y-25 | ![]() | 62.62 ± 3.27 |
| Y-26 | ![]() | 27.56 ± 1.25 |
| Y-28 | ![]() | 231.73 ± 5.84 |
| Y-29 | ![]() | 26.14 ± 2.52 |
| Y-33 | ![]() | NA |
| Y-37 | ![]() | 102.08 ± 4.36 |
| Y-38 | ![]() | >260 |
| Y-39 | ![]() | 47.44 ± 1.74 |
| Y-40 | ![]() | 180.5 ± 1.77 |
| Y-41 | ![]() | NA |
| C10-HSL | ![]() | 0.15 ± 0.024 |
| Number | Structure | IC50 (µM) |
|---|---|---|
| Y-4 | ![]() | >260 |
| Y-6 | ![]() | >260 |
| Y-10 | ![]() | NA |
| Y-20 | ![]() | NA |
| Y-22 | ![]() | NA |
| Y-31 | ![]() | 91.55 ± 3.35 |
| Y-32 | ![]() | NA |
| Y-34 | ![]() | NA |
| Y-35 | ![]() | NA |
| Concentration | 0 (μM) | 40 (μM) | 81.5 (μM) | 162.5 (μM) | |
|---|---|---|---|---|---|
| Virulence Factors | |||||
| Pyocyanin | 0% | 10% | 17.1% | 22.5% | |
| Rhamnolipid | 0% | 0.4% | 5.8% | 6.1% | |
| Elastase | 0% | 11.3% | 20.0% | 26.7% | |
| Route | Dose (mg/kg) | AUC (h × ng/mL) | T1/2 (h) | Tmax (h) | Cmax (ng/mL) | F (%) |
|---|---|---|---|---|---|---|
| IV | 5 | 935 | 0.13 | 0.08 | 3290 | NA |
| PO | 20 | 1100 | 5.18 | 0.25 | 1279 | 30.4 |
Disclaimer/Publisher’s Note: The statements, opinions and data contained in all publications are solely those of the individual author(s) and contributor(s) and not of MDPI and/or the editor(s). MDPI and/or the editor(s) disclaim responsibility for any injury to people or property resulting from any ideas, methods, instructions or products referred to in the content. |
© 2024 by the authors. Licensee MDPI, Basel, Switzerland. This article is an open access article distributed under the terms and conditions of the Creative Commons Attribution (CC BY) license (https://creativecommons.org/licenses/by/4.0/).
Share and Cite
Yan, X.; Hou, S.; Xing, C.; Zhang, Y.; Chang, J.; Xiao, J.; Lin, F. Design, Synthesis, and Biological Evaluation of the Quorum-Sensing Inhibitors of Pseudomonas aeruginosa PAO1. Molecules 2024, 29, 2211. https://doi.org/10.3390/molecules29102211
Yan X, Hou S, Xing C, Zhang Y, Chang J, Xiao J, Lin F. Design, Synthesis, and Biological Evaluation of the Quorum-Sensing Inhibitors of Pseudomonas aeruginosa PAO1. Molecules. 2024; 29(10):2211. https://doi.org/10.3390/molecules29102211
Chicago/Turabian StyleYan, Xinlin, Shi Hou, Cheng Xing, Yuanyuan Zhang, Jiajia Chang, Junhai Xiao, and Feng Lin. 2024. "Design, Synthesis, and Biological Evaluation of the Quorum-Sensing Inhibitors of Pseudomonas aeruginosa PAO1" Molecules 29, no. 10: 2211. https://doi.org/10.3390/molecules29102211
APA StyleYan, X., Hou, S., Xing, C., Zhang, Y., Chang, J., Xiao, J., & Lin, F. (2024). Design, Synthesis, and Biological Evaluation of the Quorum-Sensing Inhibitors of Pseudomonas aeruginosa PAO1. Molecules, 29(10), 2211. https://doi.org/10.3390/molecules29102211

































